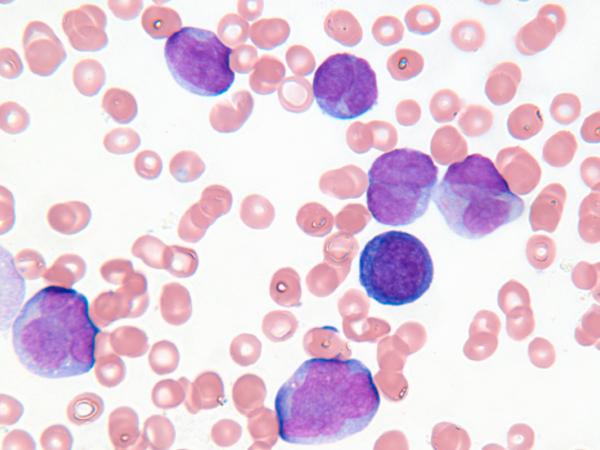
Ariad Raises $200 Million in Synthetic Royalty Financing with PDL BioPharma
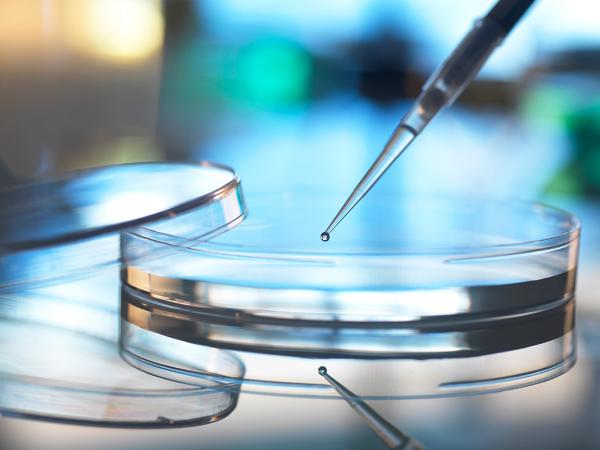
Mintz Secures Dismissal of Securities Fraud Claims Against Pharma Client

Life Sciences
 Case Study
Case Study
Mintz advised the underwriters in LB Pharmaceuticals’ $285 million IPO of 19 million shares on Nasdaq under the ticker 'LBRX'. Leerink Partners, Piper Sandler, and Stifel served as joint bookrunners.
 Case Study
Case Study
Mintz advised ArriVent BioPharma, Inc. on a $75 million underwritten public offering of 2,482,692 shares of its common stock and pre-funded warrants to purchase up to 1,363,469 shares of its common stock.
 Case Study
Case Study
Mintz advised the underwriters in connection with Assembly Biosciences, Inc.’s underwritten offering of an aggregate of 5,591,840 shares of common stock and pre-funded warrants to purchase up to 1,040,820 shares of common stock, together with accompanying Class A and Class B warrants to purchase up to an aggregate of 6,632,660 shares of common stock at a combined price per share of common stock and accompanying Class A warrant and Class B warrant of $19.60 and a combined price per pre-funded warrant and accompanying Class A warrant and Class B warrant of $19.599.
 Case Study
Case Study
Mintz advised the former shareholders of biopharmaceutical company Censa Pharmaceuticals, Inc. in the sale of their sepiapterin earnout royalty rights back to PTC Therapeutics, Inc. (NASDAQ: PTCT) in accordance with a Rights Satisfaction Agreement.
 Case Study
Case Study
Mintz advised the lead placement agent in connection with an up to $50 million private placement by Equillium, Inc.
 Case Study
Case Study
Mintz advised the underwriters in connection with a $69 million public offering by Larimar Therapeutics, Inc. of 21,562,500 shares of its common stock at a price to the public of $3.20 per share. The gross proceeds to Larimar from the offering were $69 million before deducting underwriting discounts and commissions and other offering expenses.
 Case Study
Case Study
Mintz advised the underwriters in connection with a $200 million public offering by Soleno Therapeutics, Inc. of 2,352,941 shares of its common stock at a price to the public of $85.00 per share.
 Case Study
Case Study
Mintz advised the underwriters in connection with a $230 million public offering by Cogent Biosciences, Inc. of 25,555,556 shares of common stock, which includes 3,333,333 shares issued pursuant to the exercise in full by the underwriters of their option to purchase additional shares of common stock, offered at a public offering price of $9.00 per share.
 Case Study
Case Study
Mintz advised Syntis Bio, a clinical-stage biopharmaceutical company revolutionizing oral therapies for obesity, diabetes, and rare diseases, on a $33 million oversubscribed Series A financing.
 Case Study
Case Study
Mintz represented Granata Bio Corporation, a biopharma company focused on invigorating the $3.6 billion global infertility medication market, in its $15 million Series A+ funding round.
 Case Study
Case Study
Mintz advised Relation Therapeutics, an industry leader in deploying computation and experimentation to drug discovery, on an equity investment of $15 million from GSK in connection with two simultaneous strategic collaborations with GSK, a global biopharma company. The collaborations are aimed at advancing the development of novel therapeutics for fibrotic diseases and osteoarthritis.
 Case Study
Case Study
Mintz secured a summary judgement win for client Thomas Gad, Founder and President of Y-mAbs Therapeutics, Inc., against novel Section 16(b) short-swing trading claims in the Southern District of New York.
 Case Study
Case Study
Mintz completed a $500 million senior secured credit facility for Arrowhead Pharmaceuticals on behalf of our client Sixth Street, enabling Arrowhead to fund innovation and growth opportunities across the company’s pipeline of RNAi therapeutics.
 Case Study
Case Study
Mintz advised client ArriVent BioPharma, a clinical-stage company dedicated to accelerating the global development of innovative biopharmaceutical therapeutics, on its upsized $175 million IPO on Nasdaq.
 Case Study
Case Study
Mintz represented ArriVent Biopharma in a $155 Million Series B financing led by Sofinnova Investments and General Catalyst to fund studies of the company's EGFR kinase inhibitor furmonertinib. Members Ed Pease and Private Equity Practice Co-Chair Matthew Simpson led the Mintz team's work on the transaction.
 Case Study
Case Study
 Case Study
Case Study
 Case Study
Case Study
 Case Study
Case Study
 Case Study
Case Study
 Case Study
Case Study
 Case Study
Case Study
 Case Study
Case Study
 Case Study
Case Study
 Case Study
Case Study
 Case Study
Case Study
 Case Study
Case Study
Case Study
Case Study
 Case Study
Case Study
 Case Study
Case Study
 Case Study
Case Study
 Case Study
Case Study
 Case Study
Case Study
 Case Study
Case Study
 Case Study
Case Study
 Case Study
Case Study
 Case Study
Case Study
 Case Study
Case Study
 Case Study
Case Study
 Case Study
Case Study
 Case Study
Case Study
Case Study
Case Study
 Case Study
Case Study
 Case Study
Case Study
 Case Study
Case Study
 Case Study
Case Study
 Case Study
Case Study
 Case Study
Case Study
 Case Study
Case Study
 Case Study
Case Study
 Case Study
Case Study
 Case Study
Case Study
 Case Study
Case Study
 Case Study
Case Study
 Case Study
Case Study
 Case Study
Case Study
 Case Study
Case Study
 Case Study
Case Study
 Case Study
Case Study
 Case Study
Case Study
 Case Study
Case Study
 Case Study
Case Study
 Case Study
Case Study
 Case Study
Case Study
 Case Study
Case Study

